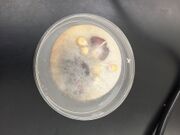
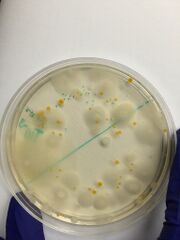

Uploads by Alexandra A. Morris
From OpenWetWare
Jump to navigationJump to search
This special page shows all uploaded files.
| Date | Name | Thumbnail | Size | Description |
|---|---|---|---|---|
| 23:39, 29 February 2016 | Gel Picture.JPG (file) |  |
10 KB | |
| 02:15, 22 February 2016 | IMG 2676.JPG (file) |  |
110 KB | |
| 02:15, 22 February 2016 | IMG 2668.JPG (file) |  |
86 KB | |
| 02:14, 22 February 2016 | IMG 0245.JPG (file) |  |
85 KB | |
| 02:14, 22 February 2016 | IMG 0228.JPG (file) |  |
115 KB | |
| 02:14, 22 February 2016 | IMG 0249.JPG (file) |  |
73 KB | |
| 02:13, 22 February 2016 | IMG 0226!.JPG (file) |  |
113 KB | |
| 02:13, 22 February 2016 | IMG 2673.JPG (file) |  |
119 KB | |
| 02:13, 22 February 2016 | IMG 2659.JPG (file) |  |
140 KB | |
| 02:12, 22 February 2016 | IMG 2661.JPG (file) |  |
260 KB | |
| 02:12, 22 February 2016 | IMG 2655.JPG (file) |  |
287 KB | |
| 02:11, 22 February 2016 | IMG 2664.JPG (file) |  |
86 KB | |
| 02:11, 22 February 2016 | IMG 2662.JPG (file) |  |
197 KB | |
| 01:57, 22 February 2016 | IMG FoodWeb.JPG (file) |  |
129 KB | |
| 02:30, 18 February 2016 | IMG 8040.JPG (file) |  |
80 KB | |
| 02:30, 18 February 2016 | IMG 8062.JPG (file) |  |
114 KB | |
| 02:29, 18 February 2016 | IMG 8053.JPG (file) |  |
192 KB | |
| 02:29, 18 February 2016 | IMG 8032.JPG (file) |  |
111 KB | |
| 02:29, 18 February 2016 | IMG 8063.JPG (file) |  |
130 KB | |
| 02:28, 18 February 2016 | IMG 1915.JPG (file) | |
150 KB | |
| 02:24, 18 February 2016 | IMG 2648.IMG (file) |  |
128 KB | |
| 02:24, 18 February 2016 | IMG 2647.IMG (file) |  |
230 KB | |
| 02:24, 18 February 2016 | IMG 2646.JPG (file) |  |
174 KB | |
| 02:23, 18 February 2016 | IMG 2645!.JPG (file) |  |
169 KB | |
| 02:20, 18 February 2016 | IMG 8036.JPG (file) |  |
42 KB | |
| 01:58, 18 February 2016 | BIO LAB TABLE 1.docx (file) | 59 KB | ||
| 00:15, 9 February 2016 | Image-7.jpg (file) |  |
464 KB | This picture is showing the 10^-3 agar plate |
| 00:14, 9 February 2016 | Image-1-1.jpg (file) |  |
482 KB | This picture is showing the 10^-5 agar plate |
| 00:14, 9 February 2016 | Image-1-2.jpg (file) | |
463 KB | This picture is showing the agar with the 10^-3 plate with the tetracycline |
| 00:13, 9 February 2016 | Image-1-3.jpg (file) |  |
462 KB | This picture is showing the agar plate for the 10^-5 dilution with tetracycline |
| 00:12, 9 February 2016 | Image-1-4.jpg (file) |  |
380 KB | This picture is depicting the 10^-3 slide |
| 00:12, 9 February 2016 | Image-1-5.jpg (file) |  |
716 KB | This picture is depicting the 10^-3 slide with tetracycline |
| 00:10, 9 February 2016 | Image-1-6.jpg (file) |  |
577 KB | 10^-5 |
| 00:09, 9 February 2016 | IMG 7974.MOV.mov (file) | 5.73 MB | ||
| 02:34, 4 February 2016 | IMG 2606.JPG (file) |  |
435 KB | |
| 02:33, 4 February 2016 | IMG 7890.JPG (file) |  |
847 KB | |
| 02:32, 4 February 2016 | IMG 2614.JPG (file) |  |
362 KB | |
| 02:32, 4 February 2016 | IMG 7891.JPG (file) |  |
951 KB | |
| 01:56, 28 January 2016 | IMG 2633.JPG (file) |  |
1.42 MB | |
| 01:42, 28 January 2016 | IMP 5855.jpeg (file) |  |
858 KB | |
| 01:42, 28 January 2016 | IMG 2596.jpeg (file) |  |
1.24 MB | |
| 01:41, 28 January 2016 | IMG 2594.jpeg (file) |  |
1.05 MB | |
| 01:41, 28 January 2016 | IMG 1538.jpeg (file) |  |
1.99 MB | |
| 01:40, 28 January 2016 | IMG 1539.jpeg (file) |  |
1.14 MB | |
| 01:40, 28 January 2016 | IMG 1168.jpeg (file) |  |
1.55 MB |